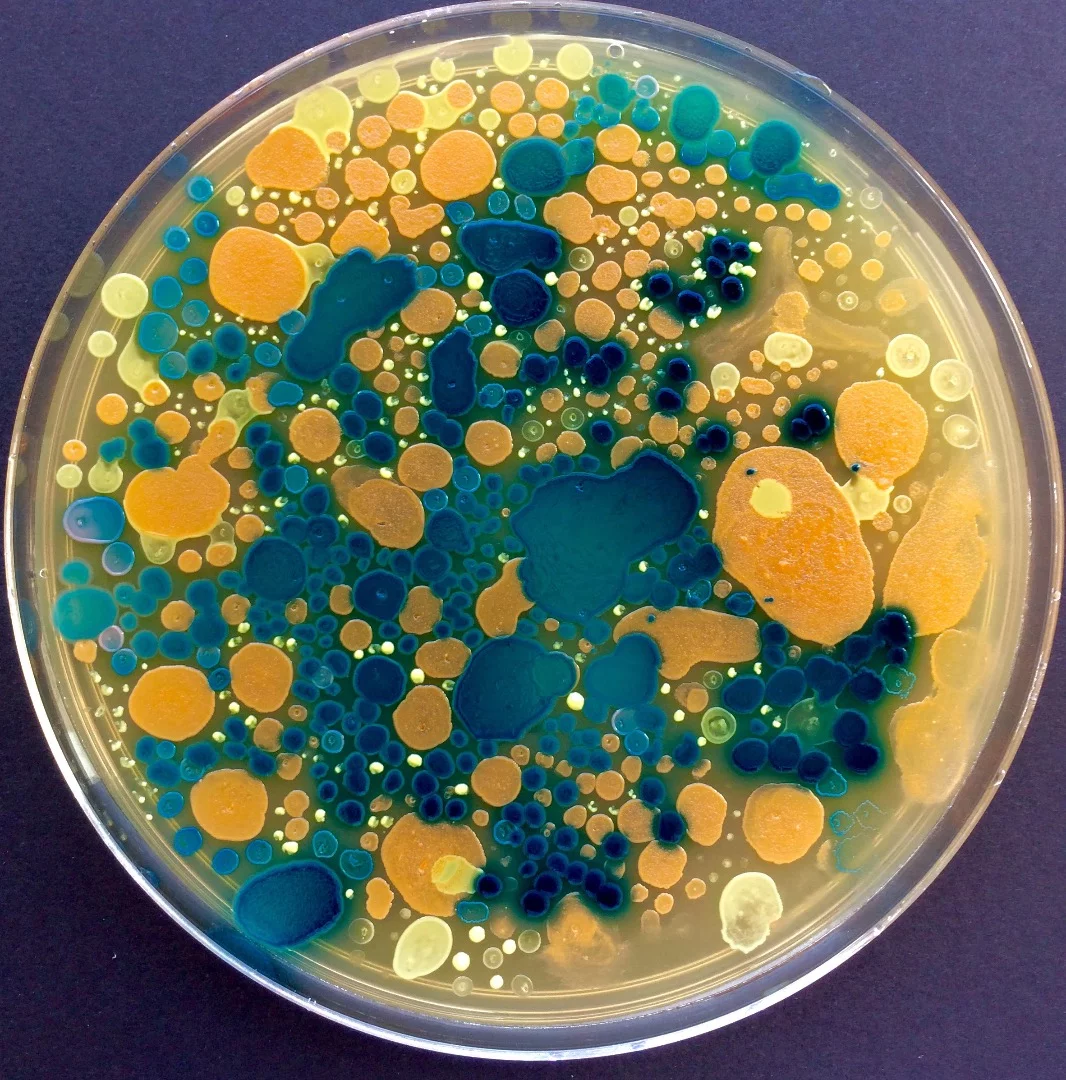
Intricate Bioart made from a variety of bacteria grown on Petri dishes by Maria Penil and Mehmet Berkmen
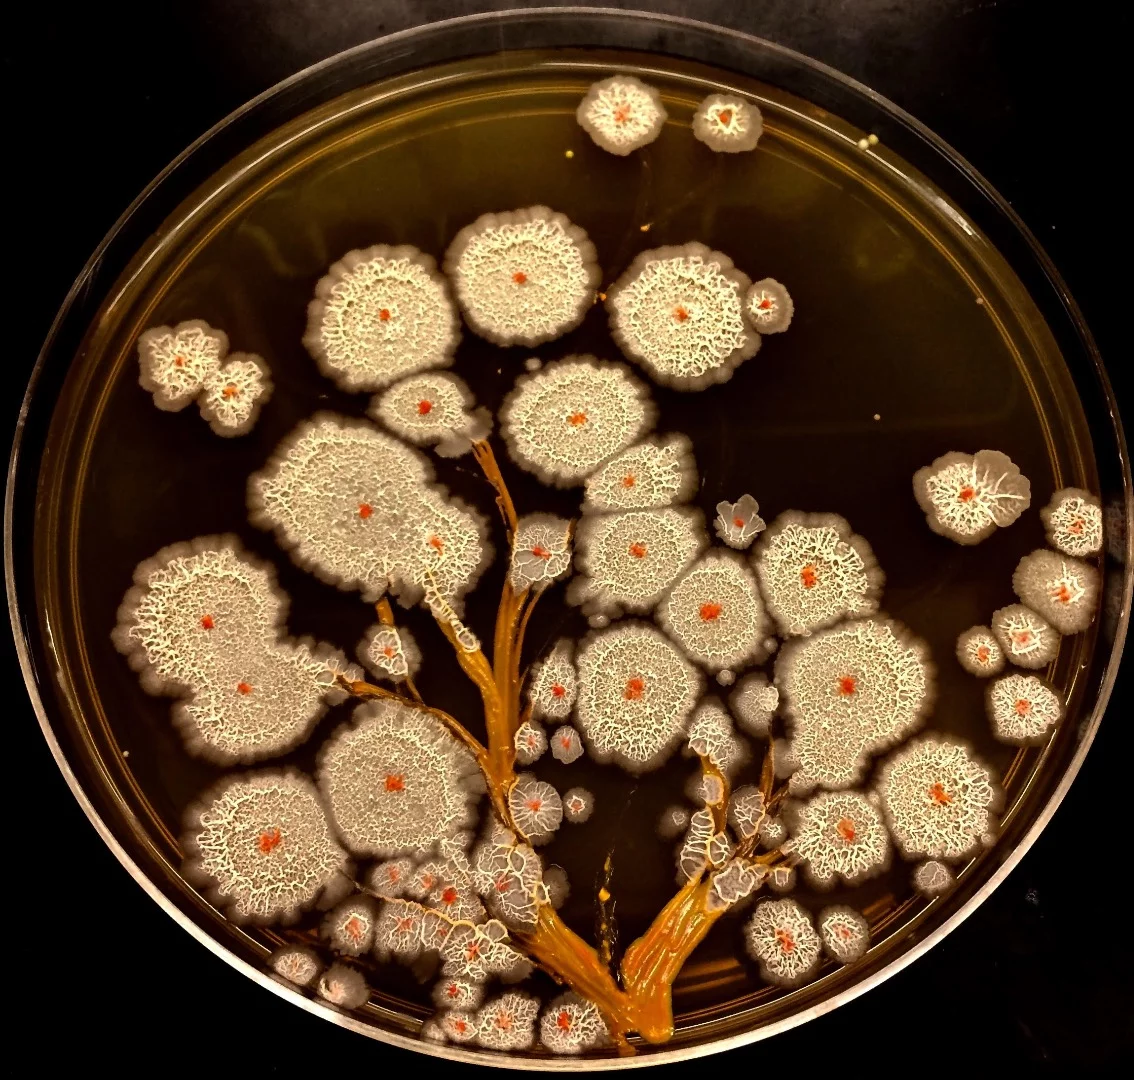
Intricate Bioart made from a variety of bacteria grown on Petri dishes by Maria Penil and Mehmet Berkmen

Art has always been fundamentally intertwined with technology. New techniques and materials have constantly allowed artists to innovate and create new types of works. Our new series, which kicked off with examinations of "datamoshing" and ASCII art, looks at the impact of digital technologies on art and looks at how artists are creating entirely new forms of art using these modern tools. In this instalment we examine the compelling and controversial field of BioArt.
As various biotechnologies evolved late in the 20th century, artists began looking to science to influence their practice. Incorporating bacteria, living tissue, biohacking and a variety of biological practices, the field of BioArt arose as the perfect intersection between art and science.

The term "BioArt" is generally tracked back to contemporary artist Eduardo Kac, who coined the name in the late 1990s. Early iconic examples of Kac's BioArt include Genesis (1999) and GFP Bunny (2000).
Genesis involved Kac translating a line from the book of Genesis into morse code and then converting that code into DNA base pairs. Dubbed the Genesis gene, Kac then incorporated the gene into bacteria, which was displayed in a gallery under ultraviolet light causing the bacteria to dynamically mutate as it was exhibited.

GFP Bunny is probably Kac's most well-known, and controversial, work, in which he genetically modified an albino bunny with a jellyfish gene, causing the bunny to glow green when exposed to a certain light. The work was extraordinarily divisive, resulting in debates surrounding the ethical questions about whether it is right to manipulate life forms for our aesthetic enjoyment.
The entire field of BioArt seems to implicitly embed these debates into the work and many BioArtists view the ethical questions as fundamental to the work.

The transhumanist culture of biohacking is often seen as a fundamental part of the BioArt field, with body-modifying performance artist Stelarc leading the way, most dramatically in 2007 when he had an ear surgically implanted into his arm. Made from a biocompatible frame, the implanted ear scaffold quickly bonded with Stelarc's own tissue and is now a permanent part of his body. He plans to continue to grow elements on it before ultimately planning on implanting a microphone that will be permanently and wirelessly connected to the internet.

Other compelling examples of BioArt include Heather Dewey-Hagborg's Stranger Visions, a work where she gathered chewed gum and cigarette butts from the street and extracted DNA from the objects. She then reconstructed what those individuals may have looked like using forensic DNA phenotyping and 3D printing.

Joe Davis, colloquially known as the mad scientist of MIT, has been a pioneer in the field of BioArt with an insane variety of projects, from genetically engineering silk worms, to spinning metallic gold as a new take on the Rumpelstiltskin fairy tale, to creating an audio microscope that translates light into sound allowing the participant to listen to bacteria.
The field of BioArt is strange, confronting and varied, but as we travel deeper into the 21st century we're sure to find artists in the field pushing the limits even further.
Take a trip some of our favorite, odd, and confronting examples of BioArt in our gallery.